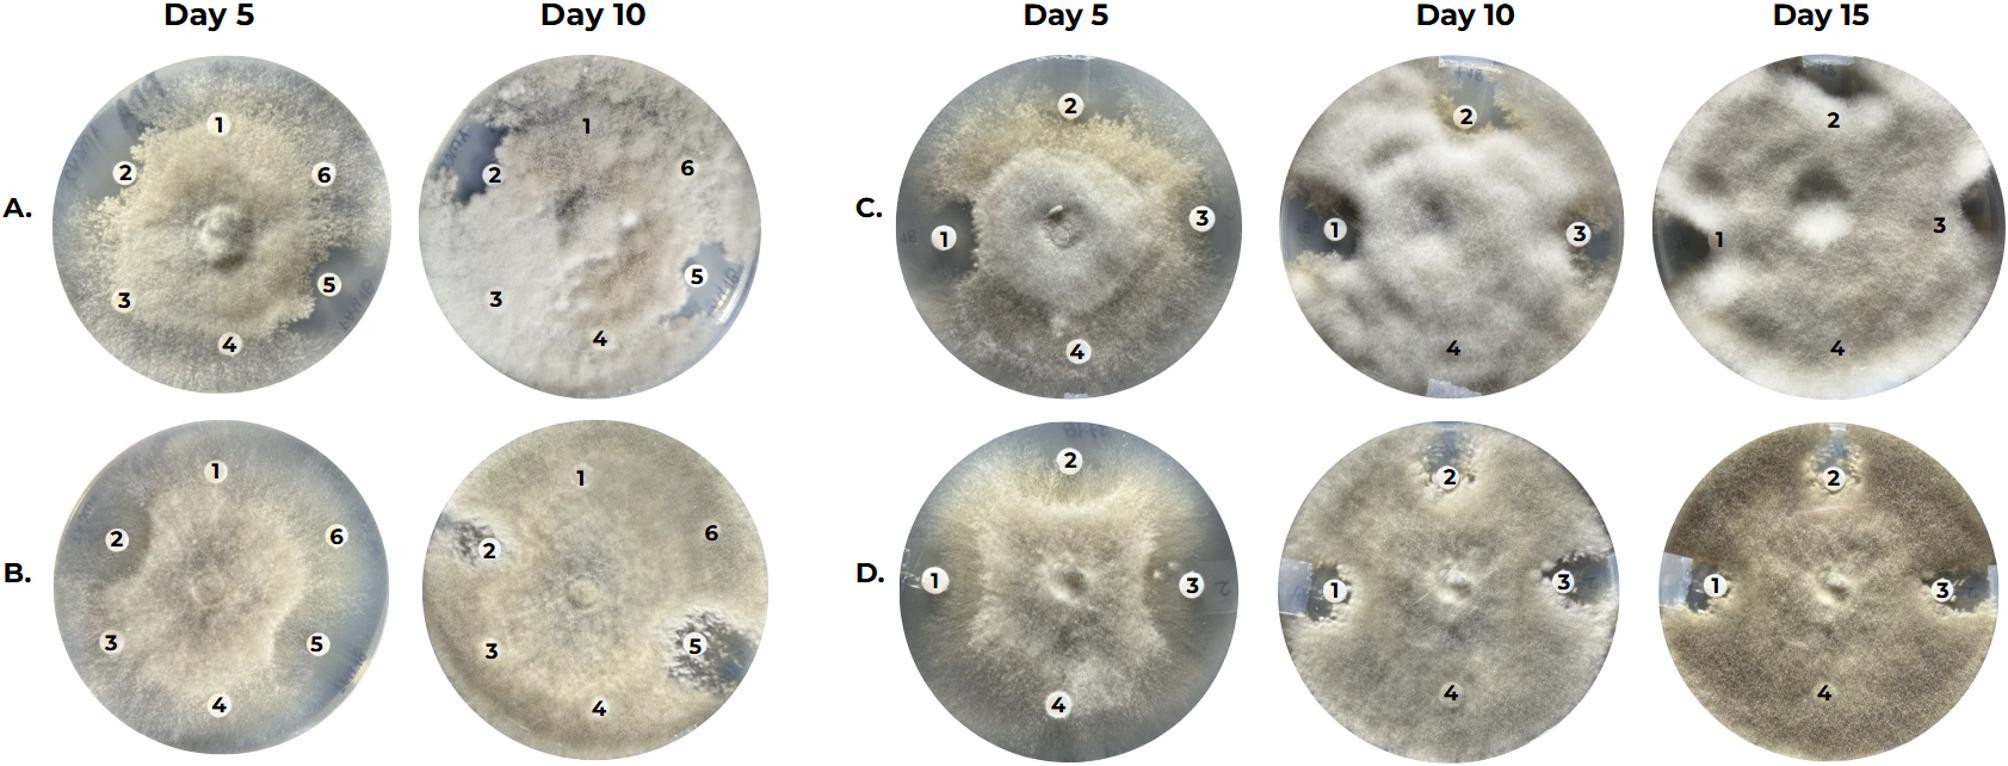
Fig. 4

Fig. 4
Antifungal activity of Bacillus lipopeptides against Botrytis cinerea. Mycelial transplant assay. The figure shows an agar plug of A. B. cinerea B05.10 mycelium and B. B. cinerea T4 in the center of a PDA Petri dish, and discs impregnated with purified lipopeptides from the five Bacillus strains and a methanol impregnated disc that serves as a negative control are positioned equidistantly at ~ 3 cm from the plug. Numbers on the plate indicate disc positions: 1 = Negative control, 2 = B. subtilis s.s. AMCV2, 3 = B. cereus s.s. TCT6, 4 = B. cereus s.s. AMCV8, 5 = B. subtilis s.s. FAU18, 6 = B. cereus s.s. FAU20. Synergy assay of lipopeptides from B. subtilis s.s. AMCV2 and B. subtilis s.s. FAU18 against Botrytis cinerea. A mycelial plug of C. B. cinerea 05.10 and D. B. cinerea T4 is in the center of the PDA Petri dish. Discs impregnated with purified lipopeptides are positioned equidistantly at ~ 3 cm from the plug. Numbers on the plate indicate disc positions: 1 = B. subtilis s.s. FAU18 (20 µL), 2 = B. subtilis s.s. AMCV2 + B. subtilis s.s. FAU18 (10 µL each), 3 = B. subtilis s.s. AMCV2 (20 µL), 4 = methanol (20 µL, negative control). Images were taken after 5, 10 and 15 days of incubation at 25 °C.
